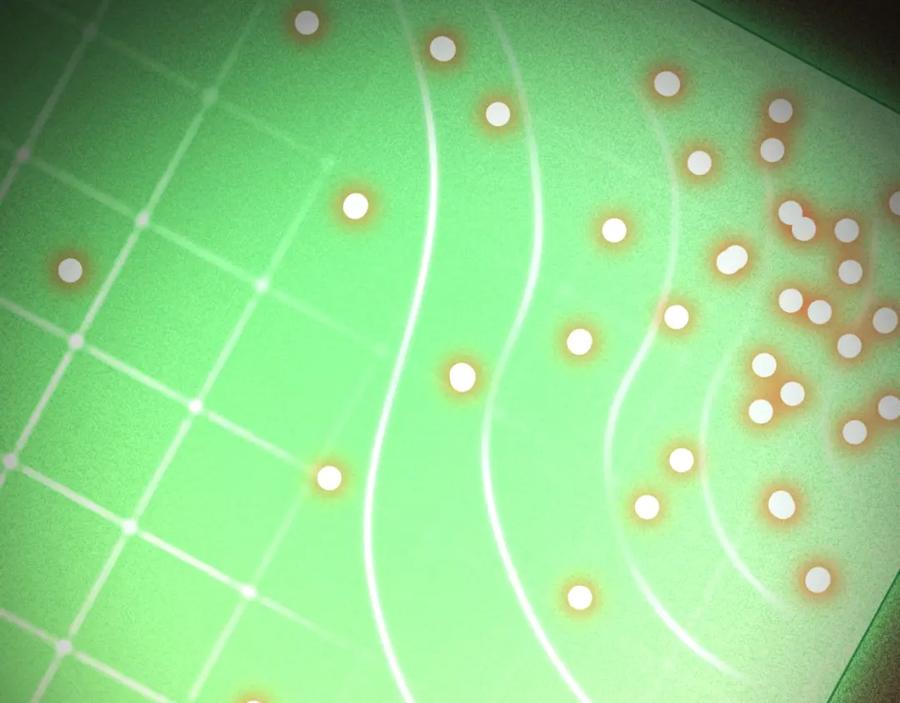

重启地下城
第166话 绝妙的办法

如果喜欢大古漫画请分享给身边的朋友,站内广告是本站能持续为大家服务的立命之本还望顺手支持一下^_^
Copyright © 2019-2024 · 大古漫画 www.dagumhw.com